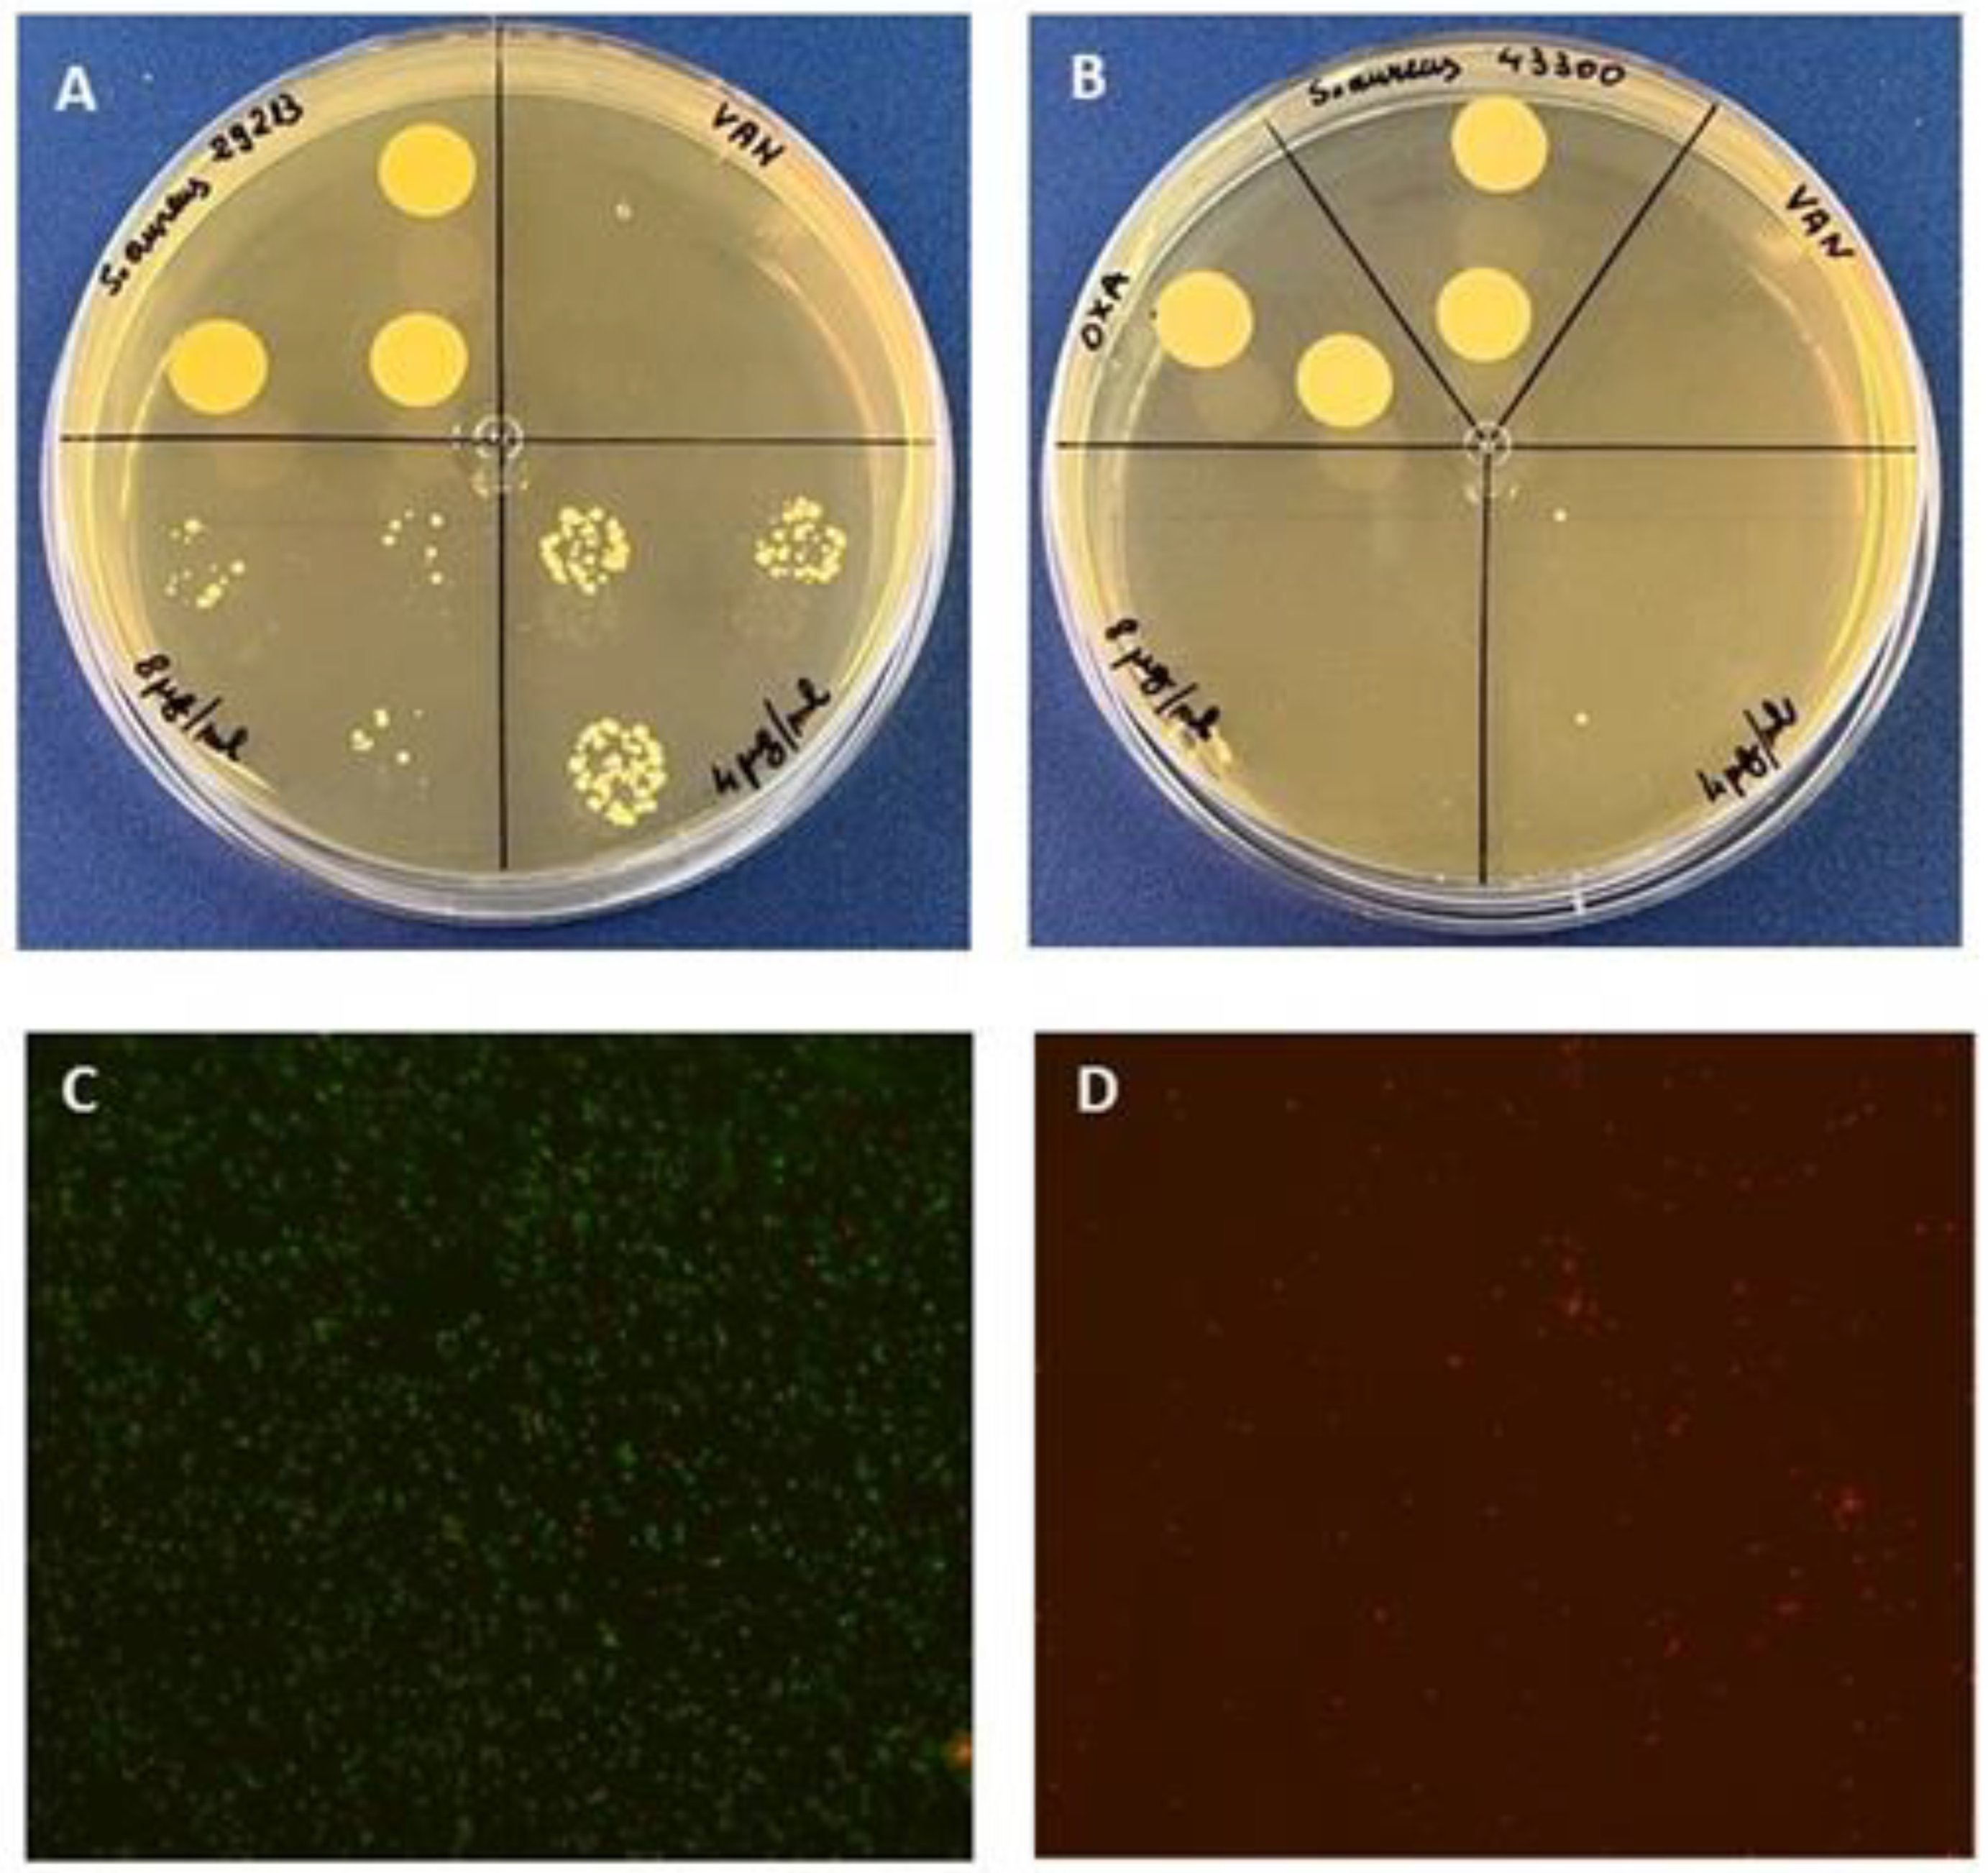
Molecules 27 07109 g003

Gallomyrtucommulones G and H, New Phloroglucinol Glycosides, from Bioactive Fractions of Myrtus communis against Staphylococcus Species
Abstract
1. Introduction
2. Results and Discussion
2.1. Antimicrobial Activity of Hydroalcholic Crude Extract and First Purification Step
2.2. Fractionation of MC_A: Antimicrobial Assessment
2.3. Fractionation of MC_B and NMR Characterization of Alkylphloroglucinol Glucosides
2.4. Fractionation of MC_B Antimicrobial Assessment
3. Materials and Methods
3.1. Plant Material
3.2. General Chromatographic Procedures
3.3. NMR Experiments
3.4. ESI MS Analyses
3.5. IR Analyses
3.6. Hydroalcoholic Extraction of M. communis Leaves and Compounds Purification
3.7. Antimicrobial Test
3.7.1. Microorganism and Growth Conditions
3.7.2. Susceptibility Assays on Bacteria Planktonic Cells
3.7.3. Live/Dead Imaging
3.7.4. Checkerboard Method
4. Conclusions
Supplementary Materials
Author Contributions
Funding
Institutional Review Board Statement
Data Availability Statement
Acknowledgments
Conflicts of Interest
Sample Availability
References
- Schommer, N.N.; Gallo, R.L. Structure and function of the human skin microbiome. Trends Microbiol. 2013, 21, 660–668. [Google Scholar] [CrossRef] [PubMed]
- Lai, Y.; Cogen, A.L.; Radek, K.A.; Park, H.J.; Macleod, D.T.; Leichtle, A.; Ryan, A.F.; Di Nardo, A.; Gallo, R.L. Activation of TLR2 by a small molecule produced by S. epidermidis increases antimicrobial defense against bacterial skin infections. J. Investig. Dermatol. 2010, 130, 2211–2221. [Google Scholar] [CrossRef] [PubMed]
- Buommino, E.; Scognamiglio, M.; Donnarumma, G.; Fiorentino, A.; D'Abrosca, B. Recent advances in natural product-based anti-biofilm approaches to control infections. Mini-Rev. Med. Chem. 2014, 14, 1169–1182. [Google Scholar] [CrossRef]
- Guzzo, F.; Scognamiglio, M.; Fiorentino, A.; Buommino, E.; D’Abrosca, B. Plant Derived Natural Products against Pseudomonas aeruginosa and Staphylococcus aureus: Antibiofilm Activity and Molecular Mechanisms. Molecules 2020, 25, 5024. [Google Scholar] [CrossRef] [PubMed]
- Liu, J.; Chen, D.; Peters, B.M.; Li, L.; Li, B.; Xu, Z.; Shirli, M.E. Staphylococcal chromosomal cassettes mec (SCCmec): A mobile genetic element in methicillin-resistant Staphylococcus aureus. Microb. Pathog. 2016, 101, 56–67. [Google Scholar] [CrossRef]
- Scognamiglio, M.; Buommino, E.; Coretti, L.; Graziani, V.; Russo, R.; Caputo, P.; Donnarumma, G.; D’Abrosca, B.; Fiorentino, A. Phytochemical investigation and antimicrobial assessment of Bellis sylvestris leaves. Phytochem. Lett. 2016, 17, 6–13. [Google Scholar] [CrossRef]
- D'Abrosca, B.; Buommino, E.; D'Angelo, G.; Coretti, L.; Scognamiglio, M.; Severino, V.; Pacifico, S.; Donnarumma, G.; Fiorentino, A. Spectroscopic identification and anti-biofilm properties of polar metabolites from the medicinal plant Helichrysum italicum against Pseudomonas aeruginosa. Bioorg. Med. Chem. Lett. 2013, 21, 7038–7046. [Google Scholar] [CrossRef] [PubMed]
- Alipour, G.; Dashti, S.; Hosseinzadeh, H. Review of pharmacological effects of Myrtus communis L. and its active constituents. Phytother. Res. 2014, 28, 1125–1136. [Google Scholar] [CrossRef]
- Macedo, J.G.F.; Rangel, J.M.L.; de Oliveira Santos, M.; Camilo, C.J.; Martins da Costa, J.G.; de Almeida Souza, M.M. Therapeutic indications, chemical composition and biological activity of native Brazilian species from Psidium genus (Myrtaceae): A review. J. Ethnopharmacol. 2021, 278, 114248. [Google Scholar] [CrossRef]
- Cao, J.Q.; Huang, X.J.; Li, Y.T.; Wang, Y.; Wang, L.; Jiang, R.W.; Ye, W.C. Callistrilones A and B, Triketone-Phloroglucinol-Monoterpene Hybrids with a New Skeleton from Callistemon rigidus. Org. Lett. 2016, 18, 120–123. [Google Scholar] [CrossRef]
- Limsuwan, S.; Trip, E.N.; Kouwen, T.R.; Piersma, S.; Hiranrat, A.; Mahabusarakam, W.; Voravuthikunchai, S.P.; van Dijl, J.M.; Kayser, O. Rhodomyrtone: A new candidate as natural antibacterial drug from Rhodomyrtus tomentosa. Phytomedicine 2009, 16, 645. [Google Scholar] [CrossRef]
- Faqueti, L.G.; Farias, I.V.; Sabedot, E.C.; Delle Monache, F.; San Feliciano, A.; Schuquel, I.T.A.; Cechinel-Filho, V.; Cruz, A.B.; Meyre-Silva, C. Macrocarpal-like compounds from Eugenia umbelliflora fruits and their antibacterial activity. J. Agric. Food Chem. 2015, 63, 8151–8155. [Google Scholar] [CrossRef] [PubMed]
- Nicoletti, R.; Salvatore, M.M.; Ferranti, P. Structures and bioactive properties of myrtucommulones and related acylphloroglucinols from myrtaceae. Molecules 2018, 23, 3370. [Google Scholar] [CrossRef] [PubMed]
- Kashman, Y.; Rotstein, A.; Lifshitz, A. The structure determination of two new acylphloroglucinols from Myrtus communis L. Tetrahedron 1974, 30, 991–997. [Google Scholar] [CrossRef]
- Celaj, O.; Duran, A.G.; Cennamo, P.; Scognamiglio, M.; Fiorentino, A.; Esposito, A.; D'Abrosca, B. Phloroglucinols from Myr-taceae: Attractive targets for structural characterization, biological properties and synthetic procedures. Phytochem. Rev. 2020, 20, 259–299. [Google Scholar]
- Khanh, P.N.; Duc, H.V.; Huong, T.T.; Son, N.T.; Ha, V.T.; Van, D.T.; Tai, B.H.; Kim, J.E.; Jo, A.R.; Kim, Y.H.; et al. Alkylphloroglucinol derivatives and triterpenoids with soluble epoxide hydrolase inhibitory activity from Callistemon citrinus. Fitoterapia 2016, 109, 39–44. [Google Scholar] [CrossRef]
- Guzzo, F.; Russo, R.; Sanna, C.; Celaj, O.; Caredda, A.; Corona, A.; Tramontano, E.; Fiorentino, A.; Esposito, F.; D'Abrosca, B. Chemical Characterization and Anti-HIV-1 Activity Assessment of Iridoids and Flavonols from Scrophularia trifoliata. Molecules 2021, 26, 4777. [Google Scholar] [CrossRef]
- Sanna, C.; Maxia, A.; Fenu, G.; Loi, M.C. So uncommon and so singular, but underexplored: An updated overview on ethnobotanical uses, biological properties and phytoconstituents of sardinian endemic plants. Plants 2020, 9, 958. [Google Scholar] [CrossRef]
- Chung, S.; Kim, Y.; Takaya, Y.; Terashima, K.; Niwa, M. Novel flavonol glycoside, 7-O-methyl mearnsitrin, from Sageretia theezans and its antioxidant effect. J. Agric. Food Chem. 2004, 52, 4664–4668. [Google Scholar] [CrossRef]
- Appendino, G.; Maxia, L.; Bettoni, P.; Locatelli, M.; Valdivia, C.; Ballero, M.; Stayry, M.; Gibbons, S.; Sterner, O. Antibacterial galloylated alkylphloroglucinol glucosides from Myrtle (Myrtus communis). J. Nat. Prod. 2006, 69, 251–254. [Google Scholar] [CrossRef] [PubMed]
- Taamalli, A.; Iswaldi, I.; Arràez-Roman, D.; Segura-Carretero, A.; Fernandez-Gutierrez, A.; Zarrouk, M. UPLC-QTOF/MS for a rapid characterization of phenolic compounds from leaves of Myrtus communis L. Phytochem Anal. 2013, 25, 89–96. [Google Scholar] [CrossRef]
- Najjar, F.; Gorrichon, L.; Baltas, M.; Andrè-Barrés, C.; Vial, H. Alkylation of natural endoperoxide G3-factor. Synthesis and antimalarial activity studies. Org. Biomol. Chem. 2005, 3, 1612–1614. [Google Scholar] [CrossRef]
- Thoendel, M.; Kavanaugh, J.S.; Flack, C.E.; Horswill, A.R. Peptide signaling in the staphylococci. Chem. Rev. 2011, 111, 117–151. [Google Scholar] [CrossRef] [PubMed]
- Yang, T.; Tal-Gan, Y.; Paharik, A.E.; Horswill, A.R.; Blackwell, H.E. Structure–Function Analyses of a Staphylococcus epidermidis Autoinducing Peptide Reveals Motifs Critical for AgrC-type Receptor Modulation. ACS Chem. Biol. 2016, 11, 1982–1991. [Google Scholar] [CrossRef]
- Vollaro, A.; Catania, M.R.; Iesce, M.R.; Sferruzza, R.; D’Abrosca, B.; Donnarumma, G.; De Filippis, A.; Cermola, F.; DellaGreca, M.; Buommino, E. Antimicrobial and anti-biofilm properties of novel syn-thetic lignan-like compounds. New Microbiol. 2019, 42, 21–28. [Google Scholar]
- Goel, S.; Mishra, P. Thymoquinone inhibits biofilm formation and has selective antibacterial activity due to ROS generation. Appl. Microbiol. Biotechnol. 2018, 102, 1955–1967. [Google Scholar] [CrossRef]
- Pillai, S.K.; Moellering, R.C.; Eliopoulos, G.M. Antimicrobial combinations. In Antibiotics in Laboratory Medicine, 5th ed.; Lippincott Williams & Wilkins: Philadelphia, PA, USA, 2005; pp. 365–440. [Google Scholar]

| Gallomyrtucommulone G (1) | Gallomyrtucommulone H (2) | |||||
|---|---|---|---|---|---|---|
| Position | δc (Type) | δH (J in Hz) | HMBC (H→C) | δc (Type) | δH (J in Hz) | HMBC (H→C) |
| 1 | 18.0 (CH3) | 1.75 s | 2, 3, 4 | 27.0 (CH2) | 2.25 q (7.5) | |
| 1a | - | - | - | 13.7 (CH3) | 0.97 t (7.5) | 2, 3 |
| 2 | 149.9 (C) | - | - | 150.4 (C) | - | - |
| 3 | 34.0 (CH2) | 1.98 q (6.0, 9.0) | 2 | 23.9 (CH3) | 1.68 s | 1, 2 |
| 3a | 11.8 (CH3) | 0.93 t (6.0) | 2, 3 | |||
| 4 | 116.8 (CH) | 5.08 s | 118.5 (CH) | 5.01 s | ||
| 5 | 83.1 (C) | - | - | 83.4 (C) | - | - |
| 6 | 210.8 (C) | - | - | 211.1 (C) | - | - |
| 7 | 56.8 (C) | - | - | 56.7 (C) | - | - |
| 8 | 216.4 (C) | - | - | 216.9 (C) | - | - |
| 9 | 49.1 (C) | - | - | 49.7 (C) | - | - |
| 10 | 88.3 (CH) | 3.90 s | 5, 6, 8, 9 | 89.0 (CH) | 3.86 s | 5, 6, 8, 9 |
| 11 | 25.6 (CH3) | 1.30 s | 6, 7, 8, 12 | 27.0 (CH3) | 1.30 s | 6, 7, 8, 12 |
| 12 | 24.9 (CH3) | 1.21 s | 6, 7, 8, 11 | 26.1 (CH3) | 1.21 s | 6, 7, 8, 11 |
| 13 | 28.1 (CH3) | 1.19 s | 8, 9, 10, 14 | 28.4 (CH3) | 1.18 s | 8, 9, 10, 14 |
| 14 | 29.5 (CH3) | 1.22 s | 8, 9, 10, 13 | 29.34 (CH3) | 1.22 s | 8, 9, 10, 13 |
| 1′ | 107.0 (CH) | 4.58 d (8.1) | 10 | 107.0 (CH) | 4.58 d (8.1) | 10 |
| 2′ | 75.8 (CH) | 3.20 t (8.1) | 75.8 (CH) | 3.20 t (8.1) | ||
| 3′ | 78.9 (CH) | 3.38 m | 78.9 (CH) | 3.38 m | ||
| 4′ | 72.3 (CH) | 3.35 ov | 72.3 (CH) | 3.35 ov | ||
| 5′ | 76.2 (CH) | 3.56 ov | 76.2 (CH) | 3.56 ov | ||
| 6′ | 65.2 (CH2) | 4.51 dd (2.4, 9.3) 4.47 dd (9.3, 11.7) | 7″ | 65.2 (CH2) | 4.51 dd (2.4, 9.3) 4.47 dd (9.3, 11.7) | |
| 1″ | 122.1 (C) | - | 122.1 (C) | - | ||
| 2″ | 110.7 (CH) | 7.07 s | 1″, 3″, 5″, 7″ | 110.7 (CH) | 7.07 s | 1″, 3″, 5″, 7″ |
| 3″ | 146.7 (C) | - | 146.7 (C) | - | ||
| 4″ | 140.8 (C) | - | 140.8 (C) | - | ||
| 5″ | 146.7 (C) | - | 146.7 (C) | - | ||
| 6″ | 110.7 (CH) | 7.07 s | 1″, 3″, 5″, 7″ | 110.7 (CH) | 7.07 s | 1″, 3″, 5″, 7″ |
| 7″ | 168.8 (C) | - | 168.8 (C) | - | ||
| Position | δc (Type) | δH (J in Hz) | HMBC (H→C) |
|---|---|---|---|
| 1 | 19.8 (CH3) | 1.81 d (1.2) | 2, 3, 4 |
| 2 | 144.6 (C) | - | - |
| 3 | 27.2 (CH3) | 1.72 d (1.5) | 1, 2, 4 |
| 4 | 119.0 (CH) | 5.14 dd (1.5, 1.2) | |
| 5 | 83.8 (C) | - | - |
| 6 | 210.8 (C) | - | |
| 7 | 56.8 (C) | - | - |
| 8 | 216.2 (C) | - | - |
| 9 | 49.9 (C) | - | - |
| 10 | 89.1 (CH) | 4.04 s | 5, 6, 8, 9, 1′ |
| 11 | 25.1 (CH3) | 1.26 s | 6, 7, 8, 12 |
| 12 | 27.6 (CH3) | 1.32 s | 6, 7, 8, 11 |
| 13 | 26.1 (CH3) | 1.33 s | 8, 9, 10, 14 |
| 14 | 28.1 (CH3) | 1.38 s | 8, 9, 10, 13 |
| 1′ | 106.6 (CH) | 4.58 d (8.1) | 10 |
| 2′ | 75.5 (CH) | 3.17 dd (8.1, 9.0) | 1′ |
| 3′ | 78.4 (CH) | 3.34 ov | |
| 4′ | 78.0 (CH) | 3.26 ov | |
| 5′ | 78.4 (CH) | 3.54 m | |
| 6′ | 62.8 (CH2) | 3.65 dd (5.6, 11.8) 3.87 dd (1.8, 11.8) |
Publisher’s Note: MDPI stays neutral with regard to jurisdictional claims in published maps and institutional affiliations. |
© 2022 by the authors. Licensee MDPI, Basel, Switzerland. This article is an open access article distributed under the terms and conditions of the Creative Commons Attribution (CC BY) license (https://creativecommons.org/licenses/by/4.0/).
Share and Cite
Guzzo, F.; Durán, A.G.; Sanna, C.; Marasco, R.; Molfetta, N.; Buommino, E.; Fiorentino, A.; D’Abrosca, B. Gallomyrtucommulones G and H, New Phloroglucinol Glycosides, from Bioactive Fractions of Myrtus communis against Staphylococcus Species. Molecules 2022, 27, 7109. https://doi.org/10.3390/molecules27207109
Guzzo F, Durán AG, Sanna C, Marasco R, Molfetta N, Buommino E, Fiorentino A, D’Abrosca B. Gallomyrtucommulones G and H, New Phloroglucinol Glycosides, from Bioactive Fractions of Myrtus communis against Staphylococcus Species. Molecules. 2022; 27(20):7109. https://doi.org/10.3390/molecules27207109
Chicago/Turabian StyleGuzzo, Francesca, Alexandra G. Durán, Cinzia Sanna, Rosangela Marasco, Nicola Molfetta, Elisabetta Buommino, Antonio Fiorentino, and Brigida D’Abrosca. 2022. "Gallomyrtucommulones G and H, New Phloroglucinol Glycosides, from Bioactive Fractions of Myrtus communis against Staphylococcus Species" Molecules 27, no. 20: 7109. https://doi.org/10.3390/molecules27207109
APA StyleGuzzo, F., Durán, A. G., Sanna, C., Marasco, R., Molfetta, N., Buommino, E., Fiorentino, A., & D’Abrosca, B. (2022). Gallomyrtucommulones G and H, New Phloroglucinol Glycosides, from Bioactive Fractions of Myrtus communis against Staphylococcus Species. Molecules, 27(20), 7109. https://doi.org/10.3390/molecules27207109

